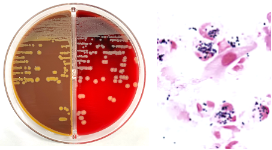
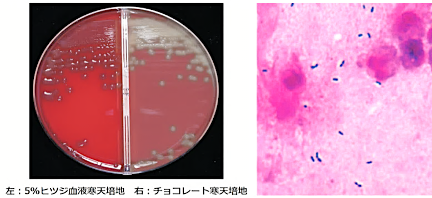
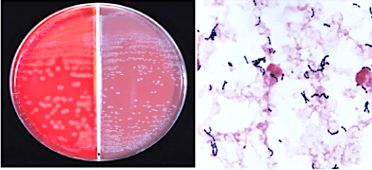
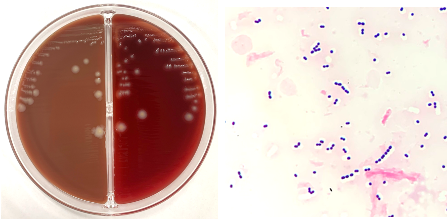
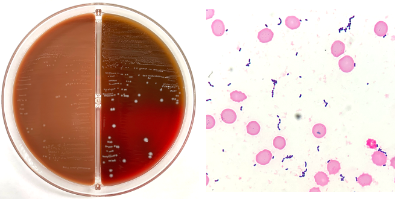
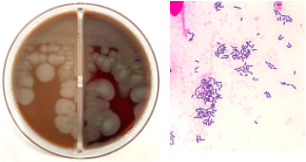
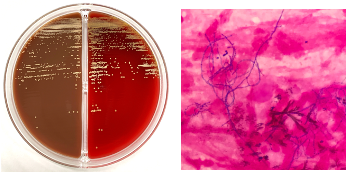
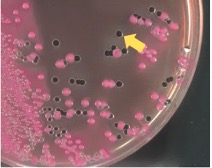
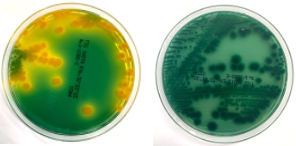

臨床微生物学の問題は個別の菌の性状を問う問題から薬剤感受性検査に関する問題など非常に多岐にわたりますが、この記事では個別の細菌の性状、特徴に関する問題から抽出した押さえておくべき事をまとめました。

菌の種類が多くてどの菌を覚えればいいの分からないという方も多いのではないでしょうか?
臨床微生物学でこれまでに出題があった個別の菌について網羅した解説なので、極端な話、この記事に載ってきることを覚えれば個別の菌の性状に関する事を問う過去問に関しては100%正答できるようになります。逆に言うと載っていない性状は覚える価値があまりないです。これまでの過去問で一度も問われていない性状になるので…
それでは、覚えて得点Getしていって下さい。
グラム陽性球菌
何からいこうか迷いましたが、定番のグラム陽性球菌から解説していきます。
国家試験で出題されるグラム陽性球菌はブドウ球菌 ( Staphylococcus属 ) とレンサ球菌 ( Streptococcus属・Enterococcus属 ) に分けられ , これらの鑑別には 3%過酸化水素水から酸素を発生するか否かをみるカタラーゼ試験が用いられる.
カタラーゼ試験 | |
Staphylococcus属 ( ブドウ球菌 ) | + |
Streptococcus属 ( レンサ球菌 ) | - |
Enterococcus属 ( レンサ球菌 ) | - |
グラム陽性球菌の個別の細菌に関する出題は上記の3属のみからの出題であり, 覚える事項も限られている.
Staphylococcus属
Staphylococcus属で個別の細菌に関する問題で出題されているのはStaphylococcus aureus ( 黄色ブドウ球菌 ) とStaphylococcus epidermidis ( 表皮ブドウ球菌 ) のみであるが , Staphylococcus aureusの性状に関連する知識ですべて解答することができるためStaphylococcus epidermidisの個別の解説は省略する.
Staphylococcus aureus ( 黄色ブドウ球菌 )
- 頻出材料:膿など ( 皮膚や鼻腔の常在菌でもある )
- マンニット ( マンニトール ) を分解するため , この特性を利用したマンニット食塩寒天培地が選択分離培地として用いられる
- Staphylococcus属にはStaphylococcus epidermidis ( 表皮ブドウ球菌 ) を含め , たくさんの種があるが , コアグラーゼ産生能の有無によりStaphylococcus aureus ( 黄色ブドウ球菌 ) とそれ以外のStaphylococcus属菌=CNS ( coagulase negative staphylococcus ) とに大きく分類され , 臨床上では圧倒的にStaphylococcus aureusが重要視される
表 Staphylococcus aureusの特徴的な性状
カタラーゼ試験 ( 過酸化水素からの酸素の発生 ) | + ( Staphylococcus属はすべて+ ) |
コアグラーゼテスト ( ウサギ血漿を凝固 ) | + |
6.5%食塩加培地での発育 ( 耐塩性 ) | + |
マンニット分解 | + |
DNase ( DNA分解酵素 ) | + |
産生する毒素 | 皮膚剥脱毒素 ( ブドウ球菌性熱傷様皮膚症候群の原因 ) エンテロトキシン ( 毒素型食中毒の原因 ) |
Streptococcus属
Streptococcus属で出題があったのはStreptococcus pneumoniae・Streptococcus pyogenes・Streptococcus agalactiaeの3種類のみである.
Streptcoccus pneumoniae ( 肺炎球菌 )
- 頻出材料:国家試験では喀痰や髄液 ( 臨床現場では圧倒的に小児の鼻汁からの分離が多い )
- 双球状で菌体の両端が横に引っ張られたような ( ランセット状 ) 形状 , 莢膜を有するためグラム染色標本では菌体周囲の色が抜けて見える
- ヒツジ血液寒天培地上でα溶血 ( 不完全溶血=集落周囲の血液寒天培地が緑色に変色 ) を示し , 集落はときにムコイド状となる
- Legionella pneumophilaと同様に尿中抗原検査がある
- 細菌性の市中肺炎の原因菌としては最多
- 髄液とその他の検査材料で感受性判定基準 ( 感性 , 中間 , 耐性 ) が異なる
表 Streptococcus pneumoniaeの特徴的な性状
カタラーゼ試験 ( 過酸化水素からの酸素の発生 ) | - ( Streptococcus属はすべて- ) |
オプトヒン | 感性 |
胆汁溶解テスト | + |
Streptococcus pyogenes ( 化膿連鎖球菌 )
- 頻出材料:咽頭
- 集落周囲にはっきりとしたβ溶血環 ( 完全溶血=集落周囲の血液寒天培地が透明になる ) がみられる
表 Streptococcus pyogenesの特徴的な性状
カタラーゼ試験 ( 過酸化水素からの酸素の発生 ) | - ( Streptococcus属はすべて- ) |
Lancefield抗原分類 | A群 ( A群β溶血性連鎖球菌 ) |
バシトラシン | 感性 |
PYR試験 | + |
産生する毒素 | 発赤毒素 ( Dick毒素 ) :猩紅熱の原因となる |
Streptococcus agalactiae
- 頻出材料:国家試験では新生児の髄液 ( 臨床現場では膣分泌物からの分離が多い )
- 集落周囲に集落と同程度の大きさの狭いβ溶血環がみられ , 同様の集落を形成する細菌にListeria monocytogenes ( グラム陽性桿菌 ) があるが , 形態 ( Streptococcus agalactiaeは球菌 ) が異なること , Streptococcus agalactiaeはBTB乳糖寒天培地には発育しないこと , カタラーゼ試験が陰性であることから鑑別できる
- E.coliやL. monocytogenesなどと同様に新生児細菌性髄膜炎の原因菌の1つである
表 Streptococcus agalactiaeの特徴的な性状
カタラーゼ試験 ( 過酸化水素からの酸素の発生 ) | - ( Streptococcus属はすべて- ) |
Lancefield抗原分類 | B群 ( B群β溶血性連鎖球菌 ) |
CAMPテスト ( S.aureusの近傍で培養すると溶血が強くなる ) | + |
馬尿酸加水分解試験 | + |
Enterococcus属
Enterococcus属に関しては , これまでに個別の性状を問う問題で出題されているのはEnterococcus faecalis ( 腸球菌 ) のみである.
Enterococcus faecalis ( 腸球菌 )
Enterococcus属の近年の出題はないが , 他の菌に関する問題で選択肢として出題されることは十分あり得るため以下の表の項目だけでも押さえておきたい.
表 Enterococcus faecalisの特徴的な性状
カタラーゼ試験 ( 過酸化水素からの酸素の発生 ) | - ( Enterococcus属はすべて- ) |
Lancefield抗原分類 | D群 |
6.5%NaCl加BHIブイヨンでの発育 | + |
胆汁エスクリン培地での発育 ( エスクリンの加水分解 ) | + |
グラム陽性桿菌 ( 嫌気性菌以外 )
嫌気性菌以外のグラム陽性桿菌の細菌について個別で問う問題は少ないが , Bacillus属が芽胞を形成する細菌であること , Nocardia属が弱抗酸性を有することは必ず覚えるべき事項である. また , Listeria monocytogenesは頻出のStreptococcus agalactiae ( グラム陽性球菌 ) とよく比較される細菌であるため , 性状についても余裕があれば覚えておきたい.
Bacillus anthracis ( 炭疽菌 )
- 菌体の中央に芽胞を形成する好気性の細菌
- 炭疽 ( 4類感染症 ) の原因菌
Bacillus cereus
- 菌体の中央に芽胞を形成する好気性の細菌
- 環境中に広く分布しているが , ときに食中毒の原因菌となる
表 Bacillus anthracisとBacillus cereusの性状
Bacillus anthracis | Bacillus cereus | |
運動性 ( 鞭毛の有無 ) | - | + |
溶血性 | - | 強いβ溶血 |
レシチナーゼテスト | + | + |
Listeria monocytogenes

- 集落と同程度の大きさの狭いβ溶血環がみられる
- E.coliやS.agalactiaeなどと同様に新生児細菌性髄膜炎の原因菌の1つである
表 Listeria monocytogenesの特徴的な性状
カタラーゼ試験 ( 過酸化水素からの酸素の発生 ) | + |
溶血性 | 弱いβ溶血 |
CAMPテスト ( S.aureusの近傍に接種すると溶血が強くなる ) | + |
運動性 ( 鞭毛の有無 ) | + |
馬尿酸塩加水分解試験 | + |
Nocardia asteroides
- 弱好酸性を有する
- Kinyoun染色 ( 抗酸菌染色 ) で染色される
- 分岐したフィラメント状のグラム陽性桿菌
通性嫌気性グラム陰性桿菌
これまでに国家試験で出題された通性嫌気性グラム陰性桿菌は① 腸内細菌科 , ② Vibrio科 , ③ Aeromonas科 , ④ Haemophilus influenzae , ⑤ Gardnerella vaginalisがある.
グラム陰性桿菌の項目は腸内細菌科を中心とした問題展開が多い. 腸内細菌科の共通性状から個々の病原菌の細かいところまで問われれている. グラム陰性桿菌の中での問題数の多さは圧倒的にSalmonella属が多く , 次いでVibrio属 ( 腸内細菌科ではない ) > Shigella属の順で多い.
① 腸内細菌科 ( 定義 )
腸内細菌科の共通性状 ( 腸内細菌の定義 ) は…
- 通性嫌気性のグラム陰性桿菌
- ブドウ糖を発酵して酸 ( または酸とガス ) を産生
- オキシダーゼテスト陰性
- 硝酸塩を亜硝酸塩に還元 ( 硝酸塩還元テスト陽性 )
- 普通寒天培地によく発育
の5項目が挙げられる.
Plesiomonas shigelloidesはオキシダーゼ試験 ( 呼吸酵素の1つ ) 陽性であるが , 腸内細菌共通抗原の保有やリボソームRNAの分析結果から腸内細菌科に分類されている.
①−1 Escherichia coli ( 大腸菌 )
- 腸管常在菌である
- 単純性膀胱炎の原因の約80%がEscherichia coliである
- 腸管出血性大腸菌 ( EHEC ) が産生する毒素にはベロ毒素があり , 腸管出血性大腸菌 ( EHEC ) 感染症は3類感染症に該当する
- 腸管出血性大腸菌 ( EHEC ) に多いO抗原 ( 耐熱性の菌体抗原 ) はO157やO26等※である
- 毒素原性大腸菌 ( ETEC ) が産生する毒素には易熱性エンテロトキシン ( LT ) と耐熱性エンテロトキシン ( ST ) がある
- 毒素を産生するEscherichia coliの中では圧倒的に腸管出血性大腸菌 ( EHEC ) が重要である
- S.agalactiaeやL. monocytogenesなどと同様に新生児細菌性髄膜炎の原因菌の1つである
※ O157やO26のすべての株がベロ毒素を産生するわけではない
表 Escherichia coliの特徴的な性状
乳糖・白糖 | + |
インドール | + |
運動性 ( 鞭毛の有無 ) | + |
ジリン脱炭酸試験 | + |
ガス産生 | + |
産生する ( 可能性のある ) 毒素 | ベロ毒素 ( EHEC ) ※ 易熱性エンテロトキシン / 耐熱性エンテロトキシン ( ETEC ) |
※ ベロ毒素には1と2がありベロ毒素1はShigella dysenteriaeが産生する志賀毒素と同じ毒素である
①−2 Salmonella属
- Salmonella属には2500種類以上の血清型や亜型があるが , 基本的にSalmonella Typhi ( チフス菌 )・Salmonella Paratyphi A ( パラチフス菌 ) とそれ以外のSalmonella属菌という3つの括りで覚えれば国家試験には対応できる
- 腸内細菌科の中でのSalmonella属の特徴は硫化水素を産生することである
- Salmonella属と同様に硫化水素を産生する腸内細菌科の細菌にProteus属とCitrobacter freundiiがあるが , これらはリジン脱炭酸試験が陰性であるという点から鑑別できる
- 上記に加え , リジン脱炭酸試験はSalmonella属の中でもSalmonella Paratyphi Aのみが陰性であるという点から , これまでの国家試験ではリジン脱炭酸試験について問われているものが圧倒的に多い
- 選択分離培地にSS寒天培地などがある
- Salmonella Typhiが引き起こす腸チフスとSalmonella Paratyphi Aが引き起こすパラチフスは3類感染症として取り扱われる
表 Salmonella属の特徴的な性状と硫化水素を産生する他の腸内細菌との比較
乳糖・白糖 | - | ||
インドール | - | ||
運動性 ( 鞭毛の有無 ) | + | ||
クエン酸塩利用能 | + ( S.TyphiとS.Paratyphi Aのみ- ) | ||
オルニチン脱炭酸試験 | + ( S.Typhiのみ- ) | ||
ガス産生 | + ( S.Typhiのみ- ) | Proteus属 | Citrobacter freundii |
ジリン脱炭酸試験 | + ( S.Paratyphi Aのみ- ) | - | - |
硫化水素産生 | + ( S.Paratyphi Aのみ- ) | + | + |
ONPGテスト | - ( S.arizonaeのみ+ ) | - | + |
①−3 Shigella属
- Shigella属にはShigella sonnei , Shigella dysenteriae , Shigella flexneri , Shigella boydiiの4種類があるが , 国家試験で出題されているのはShigella dysenteriae , Shigella sonnei , Shigella flexneriのみである
- 生化学的性状ではShigella dysenteriaeが毒素を産生するという点とShigella sonneiのみオルニチン脱炭酸試験とONPGテストが陽性 , それ以外の項目はすべて陰性というくらいの認識でよい ( Shigella属はほとんどの項目が陰性であるということが逆に特徴 )
- 選択分離培地にSS寒天培地などがある
- Shigella属菌が引き起こす細菌性赤痢は3類感染症である
表 Shigella属の特徴的な性状
Shigella dysenteriae | Shigella sonnei | Shigella flexneri | |
乳糖・白糖 | - | - | - |
インドール | d ※1 | - | d ※1 |
運動性 ( 鞭毛の有無 ) | - | - | - |
クエン酸塩利用能 | - | - | - |
オルニチン脱炭酸試験 | - | + | - |
ガス産生 | - | - | - |
ジリン脱炭酸試験 | - | - | - |
硫化水素産生 | - | - | - |
ONPGテスト | d ※1 | + | - |
産生する ( 可能性のある ) 毒素 | 志賀毒素 ※2 ( ベロ毒素 ) | なし | なし |
※1 26~75%が陽性であるが , このようなどちらとも取れる性状は不適切問題となるため国家試験では出題されない
※2 Shigella属菌とEscherichia coliは近縁種であり , Shigella dysenteriaeが産生する志賀毒素 ( ベロ毒素 ) は腸管出血性大腸菌 ( EHEC ) が産生するベロ毒素1と同じ毒素である
①-4 Yersinia属
- Yersinia属にはYersinia pestis・Yersinia enterocolitica・Yersinia pseudotuberculosisの3種類の代表的な菌があるが , 細かい性状に関する問題で出題されているのはYersinia enterocoliticaのみである
- Yersinia pestisに関しては“感染症の予防及び感染症の患者に対する医療に関する法律 ( 感染症法 )”の問で選択肢としてよく出題されている → ペストは1類感染症
- Yersinia enterocoliticaの特徴的な性状は4℃で発育が可能であること , 30℃以下でのみ運動性が陽性 , 25℃培養でVPテストが陽性 , ONPGテストが陽性である点を覚えておけばよい
- 選択分離培地にCIN寒天培地がある
表 Yersinia enterocoliticaの特徴的な性状
乳糖 / 白糖 | - / + |
インドール | d ※ |
運動性 ( 鞭毛の有無 ) | - ( 30℃以下でのみ+ ) |
クエン酸塩利用能 | - |
オルニチン脱炭酸試験 | + |
ガス産生 | - |
ジリン脱炭酸試験 | - |
硫化水素産生 | - |
VPテスト | - ( 25℃培養では+ ) |
ONPGテスト | + |
※ 26~75%が陽性であるが , このようなどちらとも取れる性状は不適切問題となるため国家試験では出題されない
①-5 Plesiomonas shigelloides
- 腸内細菌科の定義の1つである“オキシダーゼテスト陰性”という点から唯一外れている腸内細菌科細菌である
- 国家試験ではその菌の特徴となる性状を問う問題ばかりであるため , Plesiomonas shigelloidesはでオキシダーゼテストが陽性である唯一の腸内細菌科細菌であるという点さえ押さえておけばよい. 腸内細菌科の定義から外れる細菌というインパクトが大きいため , それ以外のインドールやVPといった細かい性状の記憶は不要である
- 実際にこれまでの過去問でPlesiomonas shigelloidesに関してオキシダーゼが陽性である点とブドウ糖を発酵 ( そもそも腸内細菌科細菌はすべてブドウ糖を分解 ) するという点以外のことを問われた問題はない
①-6 Serratia marcescens
- Serratia属には10種類あるが , 国家試験で問われているのはSerratia marcescensのみである
- 腸内細菌科細菌では珍しくDNaseが陽性であるため , 試験問題でもDNaseについて問われることが多い
- 生化学的性状では , Serratia marcescensはShigella属とは反対に陽性の性状が多いため , ざっくりインドールと硫化水素以外は陽性という認識でよい
表 Serratia marcescensの特徴的な性状
乳糖 / 白糖 | - / + |
インドール | - |
運動性 ( 鞭毛の有無 ) | + |
クエン酸塩利用能 | + |
オルニチン脱炭酸試験 | + |
ガス産生 | d ※ |
ジリン脱炭酸試験 | + |
硫化水素産生 | - |
VPテスト | + |
DNase ( DNA分解酵素 ) | + |
※ 26~75%が陽性であるが , このようなどちらとも取れる性状は不適切問題となるため国家試験では出題されない
①-7 Klebsiella pneumoniae / Enterobacter cloacae
Klebsiella pneumoniaeとEnterobacter cloacaeは腸内の常在菌であり , 生化学的性状も似ている点が多く一緒に出題されることが多いため , 比較しながら解説する.
- Klebsiella属でこれまでに出題されたのは , Klebsiella pneumoniaeとKlebsiella oxytocaのみであるが , 両者はインドールテストで鑑別できる
- Klebsiella属の特徴的な性状として運動性が陰性であること , 莢膜を有するためグラム染色では菌体周囲が抜けて見えることが挙げられる
- 腸内細菌科で運動性が陰性の菌にはKlebsiella属・Shigella属・Yersinia属 ( Yersinia enterocoliticaは30℃では運動性が陽性となる ) などがあるが , 腸内細菌科細菌の多くの菌は運動性が陽性であるため , 国家試験では運動性が陰性の菌は運動性に関して問われることが多い
- Klebsiella pneumoniaeとEnterobacter cloacaeで異なる性状は運動性 ( K.pneumoniaeは陰性 ) ・リジン脱炭酸試験 ( K.pneumoniaeは陽性 )・オルニチン脱炭酸試験 ( K.pneumoniaeは陰性 ) である
- VP試験に関しては運動性とは反対に多くの腸内細菌科細菌が陰性であるため , VP試験が陽性のKlebsiella属 ( K.pneumoniae / K.oxytoca ) ・Enterobacter属・Serratia属※はVP試験が陽性の細菌を問う問題でも出題される
※ Serratia属は腸内細菌科では珍しいDNaseが陽性であるという特徴もあるため , DNaseついて問われることのほうが多い
表 K.pneumoniae / K.oxytocaとE.cloacaeの特徴的な性状
Klebsiella pneumoniae / Klebsiella oxytoca | Enterobacter cloacae | |
乳糖・白糖 | + | + |
インドール | - / + | - |
運動性 ( 鞭毛の有無 ) | - | + |
クエン酸塩利用能 | + | + |
オルニチン脱炭酸試験 | - | + |
ガス産生 | + | + |
ジリン脱炭酸試験 | + | - |
硫化水素産生 | - | - |
VPテスト | + | + |
DNase ( DNA分解酵素 ) | - | - |
①-8 Proteus mirabilis / Morganella morganii
- Proteus属とMorganella属は腸内の常在菌である
- Proteus属にはProteus mirabilis・Proteus vulgaris・Proteus penneriの3種類の代表的な菌があるが , 個別の細菌に関する問題で出題されているのはProteus mirabilisのみである
- Morganella属はMorganella morganii 1種のみである
- Proteus mirabilisの特徴的な性状は寒天培地上での遊走 ( スウォーミング ) ・硫化水素産生・IPAテスト陽性である
- IPAテストは腸内細菌科の中でも限られた菌種のみ ( Proteus属・Morganella属・Providencia属 ) が陽性であり , これらの3属はリジン脱炭酸試験が陰性という共通の性状をもつ
表 P.mirabilisとM.morganii の生化学的性状
Proteus mirabilis | Morganella morganii | |
乳糖・白糖 | - | - |
インドール | - | + |
運動性 ( 鞭毛の有無 ) | + | + |
クエン酸塩利用能 | d ※ | - |
オルニチン脱炭酸試験 | + | + |
ガス産生 | + | + |
ジリン脱炭酸試験 | - | - |
硫化水素産生 | + | - |
VPテスト | d ※ | - |
DNase ( DNA分解酵素 ) | d ※ | - |
IPAテスト | + | + |
※ 26~75%が陽性であるが , このようなどちらとも取れる性状は不適切問題となるため国家試験では出題されない
② Vibrio科
- Vibrio科にはVibrio属のみが属し , 主に腸管系の病原菌で , 共通性状としてブドウ糖を発酵 , オキシダーゼテストが陽性 ( Plesiomonas属も同様であるが , Plesiomonas属は腸内細菌科 ) の特徴がある.
- 選択分離培地にTCBS寒天培地があり , 白糖分解性の違いにより培地上でコロニーの色調が異なる
- Vibrio属は基本的に極単毛 ( 一端一毛 ) を有するが , Vibrio parahaemolyticusは周毛性鞭毛を有する
表 TCBS寒天培地上でのコロニーの色調
黄色 ( 白糖分解 ) | V.cholerae・V.alginolyticus ・V.fluvialisなど |
青緑色 ( 白糖非分解 ) | V.mimicus・V.parahaemolyticus ( 腸炎ビブリオ )・V.vulnificus |
- Vibrio属には多数の菌があるが , 白糖分解性と塩化ナトリウム加ペプトン水での発育の違いにより鑑別できる
- Vibrio choleraeが原因菌となるコレラは3類感染症に該当する
- Vibrio choleraeなどの典型的なVibrio属はコンマ状の形態である ( Vibrio parahaemolyticusはコンマ状でない )
表 Vibrio属の白糖分解性と塩化ナトリウム加ペプトン水での発育
V.cholerae | V.alginolyticus | V.fluvialis | V.parahaemolyticus | V.mimicus | V.vulnificus | ||
白糖分解 | + | + | + | - | - | - | |
Nacl加ペプトン水 | 0% | + | - | - | - | + | - |
3% | + | + | + | + | + | + | |
8% | - | + | + | + | - | - | |
10% | - | + | - | - | - | - |
③ Aeromonas科
- Aeromonas科にはAeromonas属のみが属し , Vibrio科や腸内細菌科のPlesiomonas属と同様にブドウ糖を発酵 , オキシダーゼテストが陽性の特徴がある
- これまでの過去問では腸内細菌科のPlesiomonas shigelloidesと同様にAeromonas科に関してはオキシダーゼが陽性である点とブドウ糖を発酵するという点以外のことを問われた問題はないため , 細かい性状の記憶は不要である
④ Haemophilus influenzae

- 細菌性の市中肺炎の原因菌としてはStreptococcus pneumoniaeに次いで多い
- 発育にX因子 ( ヘミン ) とV因子 ( NAD ) を必要とする
- S.aureusなどのV因子を産生する菌と一緒に培養すると , S.aureusの近傍でコロニーが大きくなったり , 本来発育できないヒツジ血液寒天培地 ( NAD分解酵素が含まれる ) で発育するようになり , これを衛生現象という
- X因子およびV因子は赤血球中に含まれるため , 血液を加熱溶解させて作るチョコレート寒天培地が分離培地として用いられる
- グラム染色では小型の桿菌で多形成 ( 菌体の大きさが不揃い ) を示す
- 同属に軟性下疳 ( 日本では稀な性感染症 ) の原因となるHaemophilus ducreyiがある
- 小児の細菌性髄膜炎の原因菌となり , そのほとんどが莢膜b型 ( Hib:ヒブ ) である
表 Haemophilus influenzaeの特徴的な性状
栄養要求性 | X因子とV因子が発育に必要 |
発育培地 | チョコレート寒天培地 |
オキシダーゼテスト | + |
カタラーゼ試験 ( 過酸化水素からの酸素の発生 ) | + |
ポルフィリン試験 | - |
⑤ Gardnerella vaginalis

- Gardnerella属はグラム陰性桿菌に分類されるが , 不定性で陽性にも染色される
- 女性の膣から分離され , 細菌性膣症の原因菌とされる
- 婦人科の塗抹標本で扁平上皮細胞がGardnerella vaginalisに覆い尽くされている所見をクルーセルといい細菌性膣症を示唆する

今日はここまで!
微生物学の問題は毎年午前と午後で10問づつ出題されているので、捨てずに得点源にしたいですね!
おまけ

↑筆者が撮影した血液培養のグラム染色ですが、この連鎖球菌長すぎると思いませんか?!視野に収まっていません…微生物歴も長くなってきましたが、これは今まで見た中で最長の連鎖です…笑
国家試験にも結びつけると、血液培養陽性は緊急報告の対象ですね!
もちろん直ぐ主治医に報告しましたよ!
♦ その他のまとめ記事はこちら
♦ 過去問周回サイトはこちら